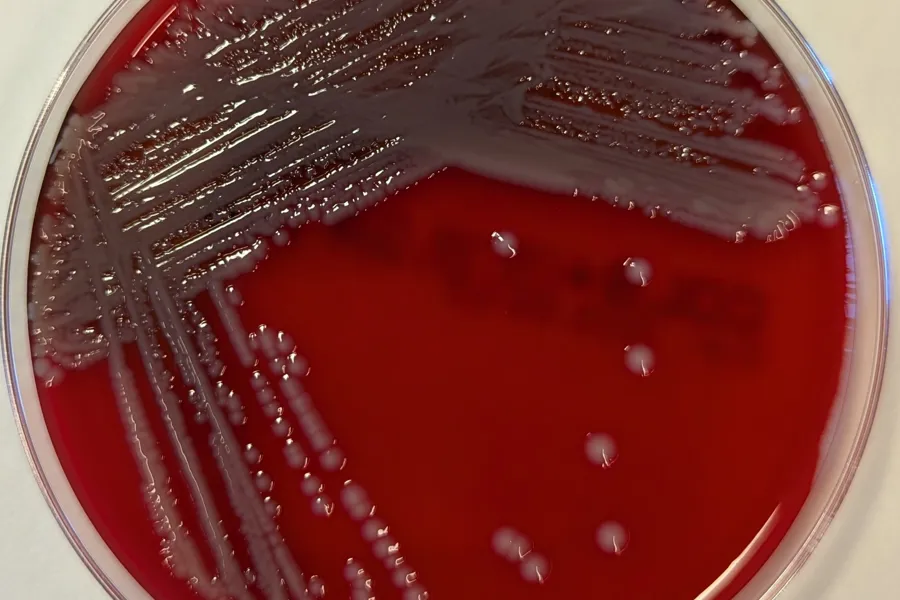

Regionalt smittevernsarbeid publisert i Eurosurveillance
Etterforskningen etter utbruddet av Serratia marcescens ved St. Olavs hospital, Helse Nord-Trøndelag og Helse Møre og Romsdal høsten 2022 er ferdigstilt og publisert i tidsskriftet Eurosurveillance.
Smittevernpersonell og personell ved de medisinsk mikrobiologiske laboratoriene i Helse Midt-Norge har vært viktige bidragsytere i etterforskningsarbeidet etter utbruddet.
- Jeg vil berømme det formidable arbeidet som er gjort i forbindelse med utbruddet av Serratia marcescens i vår region, sier helsefagdirektør Trude Basso i Helse Midt-Norge RHF.
Fakta om Serratia marcescens
Serratia marcescens er en vanlig forekommende bakterie som blant annet trives i vann og fuktige omgivelser, samt i sykehusmiljø.
Den forårsaker sjelden sykdom hos friske, men kan gi alvorlig sykdom hos pasienter med svekket immunforsvar.
Infeksjoner med Serratia marcescens kan behandles med antibiotika.
Fikk oppdrag
Etter kort tid startet Helse Midt-Norge etterforskningen av utbruddet der Regionalt kompetansesenter for smittevern (RKS) fikk i oppdrag å koordinere arbeidet på vegne av helsefagdirektør i Helse Midt-Norge RHF.
- Vi er takknemlige for å ha årvåkne kolleger som oppdaget utbruddet. Å lede utbruddsetterforskning på tvers av sykehusene i vår helseregion har vært utfordrende, men også lærerikt. Det er godt å se at samarbeidet har ført til gode prosesser med deling av informasjon og metoder for påvisning av bakterien. Vi er glade for at etterforskningen har resultert i en publikasjon i internasjonalt tidsskrift, sier medisinsk mikrobiolog Maria Schei Haugan og smittevernoverlege Nicola Isabelle Kols, koordinatorene for regional utbruddsetterforskning.
På kort tid ble det påvist flere tilfeller av smitte andre steder i Norge og Folkehelseinstituttet tok derfor over det koordinerende arbeidet for en nasjonal utbruddsetterforskning. RKS beholdt koordineringsledelse i egen helseregion.
Resultatet
Ved etterforskningens slutt i februar 2023 var det totalt 74 tilfeller, men smittekilden var fortsatt ikke funnet. Siden jobbet etterforskningsgruppen med publikasjon av funn og betraktninger fra Helse Midt-Norge.
Vår helseregion har gjort en formidabel innsats i to påfølgende nasjonale utbrudd, hhv. utbrudd med Pseudomonas aeruginosa i kontaminerte vaskekluter (okt. 2021-apr. 2022) og utbruddet med Serratia marcescens.
Her finner du publikasjonen “A national outbreak of Serratia marcescens" Eurosurveillance